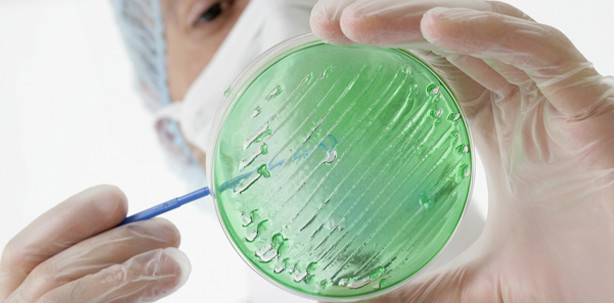
Plazenta enthält orale Bakterien

Wissenschaft und Forschung 30.05.2014
Plazenta enthält orale Bakterien
Amerikanische Forscher haben in einer Studie untersucht, welche Bakterien Bestandteil der Plazenta sind. Dabei fanden sie Bakterien, die normalerweise im menschlichen Mund vorkommen. Neben Proteobakterien fanden sie Stämme von Fusobakterien.
Diese Bakterien finden sich an Mandeln, Zunge und auch direkt an den Zähnen. Sie gelangen offenbar bereits in einem frühen Stadium der Schwangerschaft über das Blut der Mutter in die Plazenta. Somit ergeben sich auch neue Erkenntnisse, ab wann ein Baby mit den Bakterien der Mutter erstmals in Kontakt kommt.
Für die Studie wurden 320 Plazenten direkt nach der Geburt analysiert.
Quelle: Der Standard